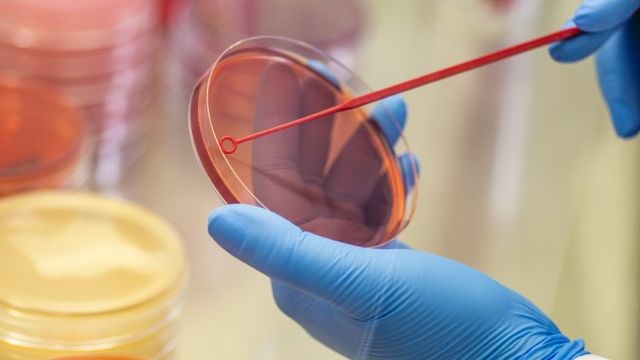

Trwa głosowanie na najlepszy innowacyjny projekt startujący w konkursie Regio Stars 2020! Do 9 lipca można oddać głos na stronie https://regiostarsawards.eu
Co roku Komisja Europejska nagradza najbardziej innowacyjne projekty finansowane z funduszy europejskich. Wśród wyróżnionych projektów z całej Europy jest 30 polskich inwestycji, które mają szanse na zwycięstwo w tym prestiżowym konkursie!
Są wśród nich także cztery opolskie projekty, które otrzymały dofinansowanie z Regionalnego Programu Operacyjnego Województwa Opolskiego:
MovieBird – GYROSCOPIC SYSTEM OF THE CAMERA CRANE
„Mission Impossible”, „Gra o Tron” to tylko niektóre filmy najlepszych producentów wykorzystujących dźwigi kamerowe firmy Moviebird z Opola. Firma zbudowała w Opolu centrum badawczo-rozwojowe przy dofinansowaniu UE, a także stworzyła żyroskopowo stabilizowany system korygujący odchylenia hydraulicznego ramienia wysięgnika kamerowego w ruchu za pomocą żyroskopowej głowicy samopoziomującej. Jest to rodzaj wysięgnika kamery, innowacyjny w przemyśle filmowym, który stabilizuje obraz podczas pościgu.
KofeinaOpole – DEVELOPMENT OF GREEN COFFEE BEAN STORAGE
Firma opracowała modelowy magazyn zielonych ziaren kawy wraz z wieloma komorami, które zapewniają różne ustawienia temperatury do przechowywania surowych ziaren kawy. Technologia koncentruje się na procesie utrzymywania poziomu związków organicznych, aktywnych i lotnych występujących w zielonych – nieprażonych – ziarnach kawy. Utrzymywanie większej liczby tych związków w procesach przechowywania i suszenia zapewnia klientowi lepszą filiżankę kawy. Rośnie liczba świadomych konsumentów, którzy chcą wysokiej jakości kawy bez względu na to, gdzie mieszkają. Projekt wychodzi naprzeciw potrzebom konsumentów i producentów kawy na całym świecie. Ma międzynarodowe znaczenie i wymiar.
Ladrob – PROBIOTICS INSTEAD OF ANTIBIOTICS
Mięso drobiowe jest jednym z najpopularniejszych produktów spożywczych. Jest szeroko dostępne, niedrogie i produkowane masowo. Jednak masowa produkcja powoduje, że wielu producentów w celu ograniczenia ryzyka biznesowego stosuje antybiotyki w hodowli drobiu. Przekłada się to na jakość produktu i jego wpływ na ludzkie ciało. Projekt firmy Ladrob rozwiązuje ten problem. Jego celem było opracowanie probiotyków i mieszanek ziołowych, które mogą zastąpić potrzebę stosowania antybiotyków w hodowli drobiu.
ALCOR Research and Production Centre – Development of a production of ODSALAX
Utrzymanie bezpieczeństwa drogowego w zimie wymaga użycia soli drogowej. Jednak nadmiar soli jest szkodliwy dla roślin. Innowacyjna technologia Centrum Badawczo-Produkcyjnego ALCOR, której opracowanie dofinansowane zostało z Opolskiego Programu Operacyjnego RPO WO 2014-2020, to produkt, który pomoże rozwiązać ten problem. Dzięki zastosowaniu opatentowanego przez ALCOR w 2018 r. Systemu ODSALAX, łatwy w montażu i demontażu absorber wydobywa szkodliwą sól z gleby, a nawet umożliwia jej recykling.
Polskie projekty rywalizują we wszystkich kategoriach konkursowych:
- Transformacja przemysłowa na rzecz inteligentnej Europy (Industrial Transition for a smart Europe)
- Gospodarka o obiegu zamkniętym dla zielonej Europy (Circular Economy for a Green Europe)
- Umiejętności i edukacja dla cyfrowej Europy (Skills and education for a digital Europe)
- Zaangażowanie obywateli na rzecz spójnych miast europejskich (Citizens engagement for cohesive European Cities)
- Temat roku 2020: Wzmocnienie pozycji młodzieży w ramach współpracy ponad granicami – 30-lecie INTERREG (Youth empowerment for cooperation across borders – 30 years of Interreg)
Z każdej kategorii konkursowej do finału jury wybierze maksymalnie pięć projektów. Również Internauci mogą zagłosować maksymalnie pięć razy na wybrany projekt.
Oprócz nagród w pięciu kategoriach przyznana zostanie Nagroda Publiczności. Publiczność wyłoni laureata w dwóch etapach: wskazując ulubione projekty spośród nominowanych, a następnie głosując jedynie na finalistów wybranych przez jury konkursu. Laureatem Public Choice Award zostanie ten finalista, który otrzyma największą liczbę głosów w obu etapach.
Ceremonia wręczenia nagród REGIOSTARS ma odbyć się w Brukseli w październiku 2020 roku. Zwycięzcy oprócz filmu promocyjnego, pucharu oraz cerytikatu REGIOSTARS 2020 otrzymają płatne partnestwo medialne o wartości 5 000 euro.
Dodatkowe informacje o konkursie REGIOSTARS znajdziesz na stronie Komisji Europejskiej.